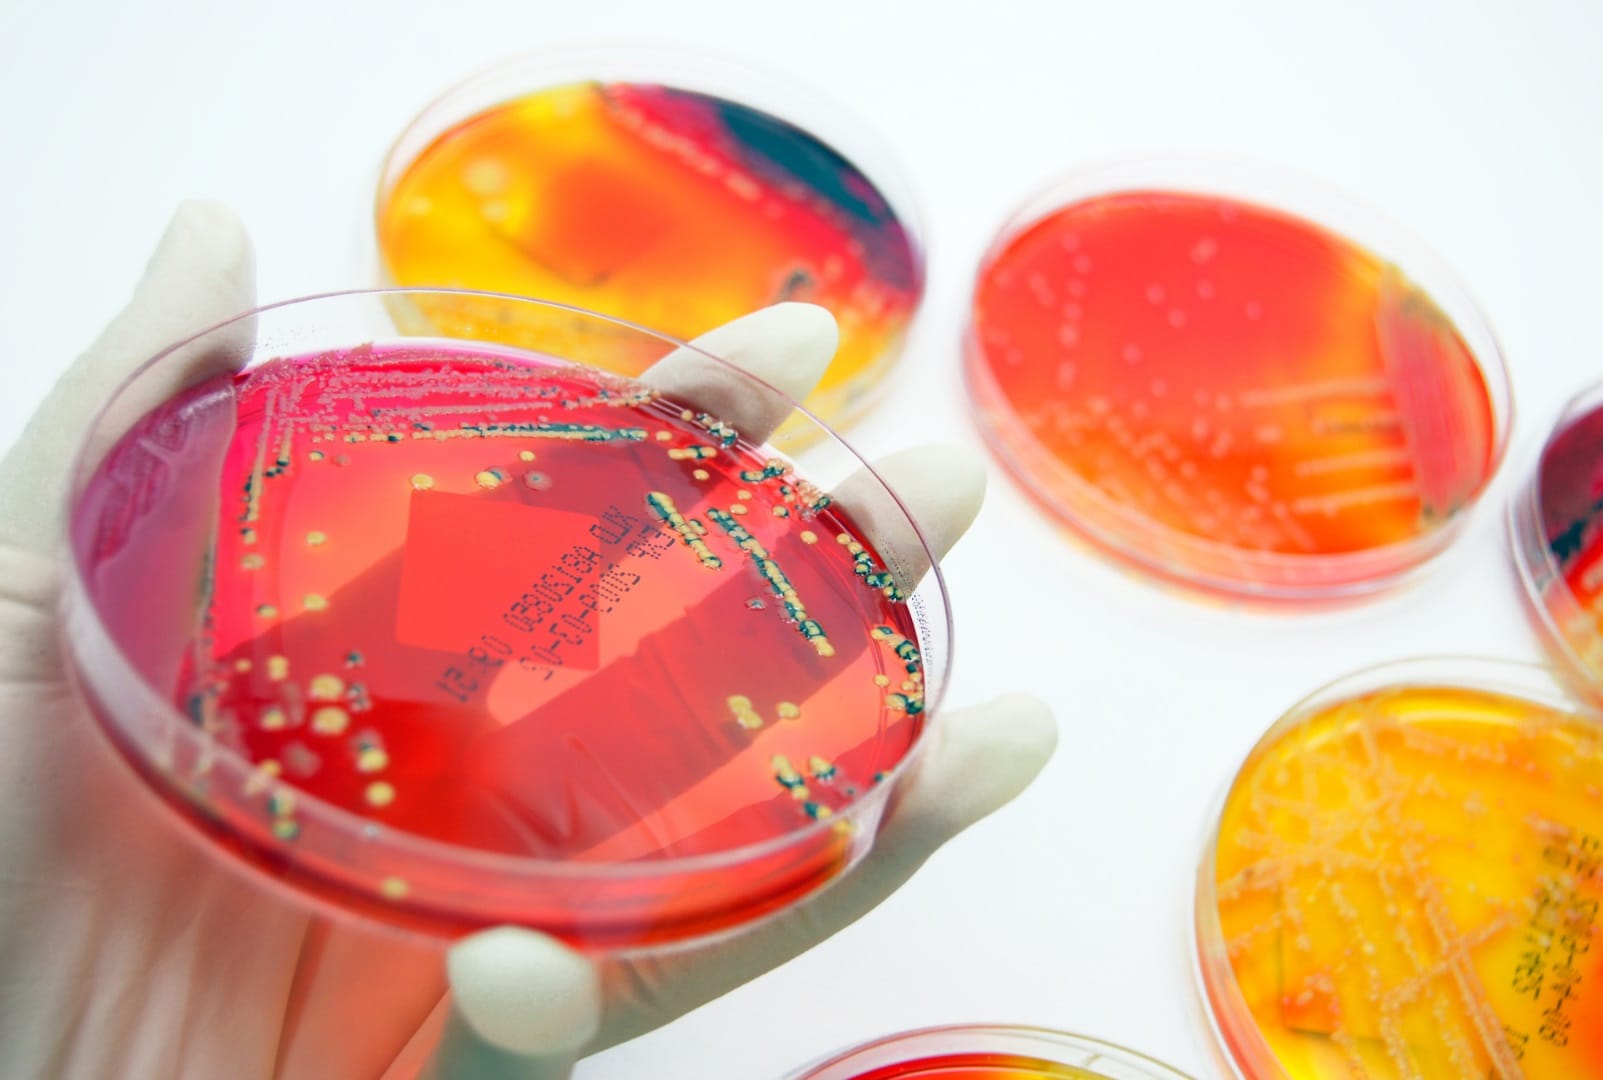

Indicaciones por análisis
Infórmate sobre las indicaciones para prácticas especiales
En nuestro compromiso por ofrecerte un servicio de máxima calidad, hemos preparado una serie de documentos detallados con las instrucciones necesarias para que puedas realizar las prácticas especiales que necesitas. Queremos asegurarnos de que tengas toda la información al alcance de tu mano.